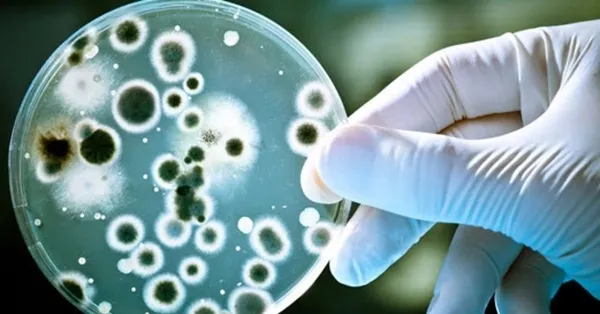
brusella-bakterisi-nedir-brusella-bakterisi-nasil-bulasir-brusella-belirtileri-nelerdir-1600523780531.jpg

Brusella bakterisi nedir? Brusella bakterisi nasıl bulaşır? Brusella belirtileri nelerdir?
Brusella belirtileri nelerdir? Brusella bakterisi nasıl bulaşır? Brusella bakterisi nedir? Çin’de ortaya çıkan bruella bakterisi tüm dünyada korkuya yol açtı. Aylardır tüm dünyanın dengesini bozan koronvirüs hastalığı nedeniyle yüzbinlerce kişi hayatını kaybetti. Peki, Brusella bakterisi nasıl bulaşır? Brusella belirtileri nelerdir? İşte, brusella bakterisi hakkında merak edilenler!
Brusella bakterisi nasıl bulaşır? Brusella belirtileri nelerdir? Brusella nedir? Çin'in Lanzhou kentinde ilk kez geçen yaz bir ilaç firmasının tesislerinden yayılan "brusella" bakterisinin şu ana kadar 3 bin 245 kişiye bulaştığı belirlendi. Ülkemizde de merak konusu olan brusella bakterisi nedir sorusuna yanıt aranıyor. İşte, brusella bakterisi hakkında merak edilen bilgiler!
BRUSELLA BAKTERİSİ NEDİR?
Brusella hastalığı, insanlarda çiğ et ve pastörize edilmemiş süt içerebilen kontamine yiyecekler nedeniyle yayılabiliyor.
Brusella ayrıca, sığır, koyun, keçi, domuz, köpek gibi hayvanlardan insanlara bulaşabilen bir hastalık olarak biliniyor. Patojen bakteriler vücuda enfekte hayvanın eti, sütü, idrarı veya dışkısı ile doğrudan temas sonucu girebiliyor,
Hastalığın belirtileri arasında ateş, yorgunluk terleme, kas, eklemler ve veya karında ağrıları, iştah ve kilo kaybı ile öksürük ve baş ağrısı gösteriliyor.
BRUSELLA NASIL BULAŞIR?
Brusella hastalığı insanlara enfekte hayvan ya da hayvan ürünü ile temas sonucu bulaşır. Hastalığın kişiden kişiye bulaşması çok nadir görülen bir durumdur. Fakat emziren annelerden anne sütü yoluyla bebeklerine geçebilir. Brusellanın bulaşma yolları arasında şunlar sayılabilir;
-Pastörize edilmemiş süt veya az pişmiş et gibi hasta hayvana ait besinler yoluyla
-Ciltte bulunan kesik, çizik gibi açık yaralardan hasta hayvanın etiyle temas sonucunda,
-Brusella bakterisi ile kontamine kirli havadan solunum yoluyla
-Göze enfekte hayvan sıvılarının teması ile
-Cinsel temas yoluyla kişiden kişiye (nadiren)

İnsanlarda brusella hastalığına en sık neden olan 4 grup bakteri türü vardır:
B. abortus: Sığırlardan bulaşır.
Brusella melitensis: Koyun ve keçilerde bulunur.
B. Suis: Yabani domuzlarda bulunan bu suş, brusella enfeksiyonlarında en etken bakteri türüdür.
B. canis: Bu tür bakterilerin enfeksiyonları köpeklerden yayılır.